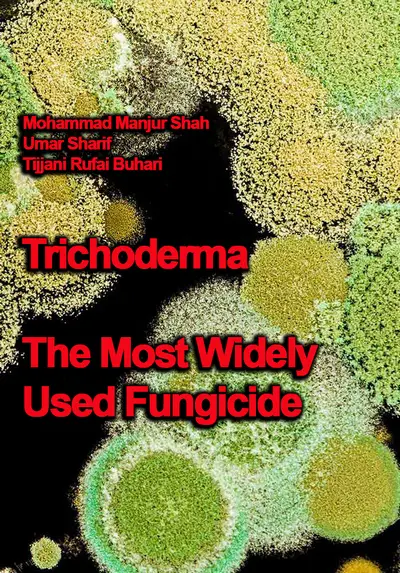

"Trichoderma: The Most Widely Used Fungicide" ed. by Mohammad Manjur Shah, Umar Sharif, Tijjani Rufai Buhari
ITExLi | 2019 | ISBN: 1789239184 9781789239188 1789239176 9781789239171 1838818553 9781838818555 | 97 pages | PDF | 6 MB
ITExLi | 2019 | ISBN: 1789239184 9781789239188 1789239176 9781789239171 1838818553 9781838818555 | 97 pages | PDF | 6 MB
This book provides comprehensive information on Trichoderma and its use in medical, agricultural and industrial applications.
Trichoderma is a genus of fungi that are present in all soils, where they are the most prevalent culturable fungi. They are also the most successful biofungicides used in today's agriculture. These green-colored fungi are well known for their antifungal and plant-growth-stimulating effects.
Section I focuses mainly on identification of Trichoderma species, and Section II is concerned with Trichoderma as a biological control agent. Chapters in these sections cover topics ranging from taxonomic status and biodiversity to biochemical analysis and bio-control application.
Contents
1.Introductory Chapter: Identification and Isolation of Trichoderma spp. - Their Significance in Agriculture, Human Health, Industrial and Environmental Application
2.Trichoderma: Invisible Partner for Visible Impact on Agriculture
3.Trichoderma as a Biocontrol Agent against Sclerotinia Stem Rot or White Mold on Soybeans in Brazil: Usage and Technology
4.A Review Study on the Postharvest Decay Control of Fruit by Trichoderma
5.A Review Report on the Mechanism of Trichoderma spp. as Biological Control Agent of the Basal Stem Rot (BSR) Disease of Elaeis guineensis
6.Trichoderma harzianum Rifai: A Beneficial Fungus for Growth and Development of Abroma augusta L. Seedlings with Other Microbial Bio-Inoculants
1st true PDF with TOC BookMarkLinks